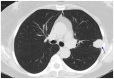

Overview of the Current Challenges in Pulmonary Coccidioidomycosis
- PMID: 39452676
- PMCID: PMC11508864
- DOI: 10.3390/jof10100724
Overview of the Current Challenges in Pulmonary Coccidioidomycosis
Abstract
Coccidioidomycosis is a disease caused by soil fungi of the genus Coccidioides, divided genetically into Coccidioides immitis (California isolates) and Coccidioides posadasii (isolates outside California). Coccidioidomycosis is transmitted through the inhalation of fungal spores, arthroconidia, which can cause disease in susceptible mammalian hosts, including humans. Coccidioidomycosis is endemic to the western part of the United States of America, including the central valley of California, Arizona, New Mexico, and parts of western Texas. Cases have been reported in other regions in different states, and endemic pockets are present in these states. The incidence of reported cases of coccidioidomycosis has notably increased since it became reportable in 1995. Clinically, the infection ranges from asymptomatic to fatal disease due to pneumonia or disseminated states. The recognition of coccidioidomycosis can be challenging, as it frequently mimics bacterial community-acquired pneumonia. The diagnosis of coccidioidomycosis is frequently dependent on serologic testing, the results of which can take several days or longer to obtain. Coccidioidomycosis continues to present challenges for clinicians, and suspected cases can be easily missed. The challenges of coccidioidomycosis disease, from presentation to diagnosis to treatment, remain a hurdle for clinicians, and further research is needed to address these challenges.
Keywords: coccidioidomycosis; lung mass; pulmonary nodules; pyopneumothorax; valley fever.
Conflict of interest statement
The author declares no conflicts of interest.
Figures

References
-
- Center for Disease Control and Prevention Valley Fever Map. [(accessed on 11 October 2024)]; Available online: https://www.cdc.gov/fungal/pdf/more-information-about-fungal-maps-508.pdf.
Publication types
LinkOut - more resources
Full Text Sources